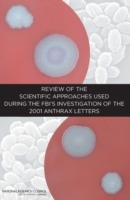
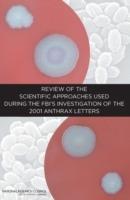

L’articolo è stato aggiunto alla lista dei desideri
IBS.it, l'altro eCommerce
Review of the Scientific Approaches Used During the FBI's Investigation of the 2001 Anthrax Letters
Cliccando su “Conferma” dichiari che il contenuto da te inserito è conforme alle Condizioni Generali d’Uso del Sito ed alle Linee Guida sui Contenuti Vietati. Puoi rileggere e modificare e successivamente confermare il tuo contenuto. Tra poche ore lo troverai online (in caso contrario verifica la conformità del contenuto alle policy del Sito).
Grazie per la tua recensione!
Tra poche ore la vedrai online (in caso contrario verifica la conformità del testo alle nostre linee guida). Dopo la pubblicazione per te +4 punti
Altre offerte vendute e spedite dai nostri venditori

Tutti i formati ed edizioni
Less than a month after the September 11, 2001 attacks, letters containing spores of anthrax bacteria (Bacillus anthracis, or B. anthracis) were sent through the U.S. mail. Between October 4 and November 20, 2001, 22 individuals developed anthrax; 5 of the cases were fatal. During its investigation of the anthrax mailings, the FBI worked with other federal agencies to coordinate and conduct scientific analyses of the anthrax letter spore powders, environmental samples, clinical samples, and samples collected from laboratories that might have been the source of the letter-associated spores. The agency relied on external experts, including some who had developed tests to differentiate among strains of B. anthracis. In 2008, seven years into the investigation, the FBI asked the National Research Council (NRC) of the National Academy of Sciences (NAS) to conduct an independent review of the scientific approaches used during the investigation of the 2001 B. anthracis mailings. Review of the Scientific Approaches Used During the FBI's Investigation of the Anthrax Letters evaluates the scientific foundation for the techniques used by the FBI to determine whether these techniques met appropriate standards for scientific reliability and for use in forensic validation, and whether the FBI reached appropriate scientific conclusions from its use of these techniques. This report reviews and assesses scientific evidence considered in connection with the 2001 Bacillus anthracis mailings. Table of Contents Front Matter Summary 1 Introduction 2 Biology and History of Bacillus anthracis 3 Scientific Investigation in a Law Enforcement Case and Description and Timeline of the FBI Scientific Investigation 4 Physical and Chemical Analyses 5 Microbiological and Genetic Analyses of Material in the Letters 6 Comparison of the Material in the Letters with Samples in the FBI Repository Bibliography Index of Documents Provided by the Federal Bureau of Investigation Appendix A: Radiocarbon Dating Appendix B: The Forensics Potential of Stable Isotope Analysis Appendix C: Committee Evaluation of Statistical Analysis Report Appendix D: Biographical Information of Committee and Staff Index
L'articolo è stato aggiunto al carrello
Le schede prodotto sono aggiornate in conformità al Regolamento UE 988/2023. Laddove ci fossero taluni dati non disponibili per ragioni indipendenti da IBS, vi informiamo che stiamo compiendo ogni ragionevole sforzo per inserirli. Vi invitiamo a controllare periodicamente il sito www.ibs.it per eventuali novità e aggiornamenti.
Per le vendite di prodotti da terze parti, ciascun venditore si assume la piena e diretta responsabilità per la commercializzazione del prodotto e per la sua conformità al Regolamento UE 988/2023, nonché alle normative nazionali ed europee vigenti.
Per informazioni sulla sicurezza dei prodotti, contattare productsafetyibs@feltrinelli.it
L’articolo è stato aggiunto alla lista dei desideri